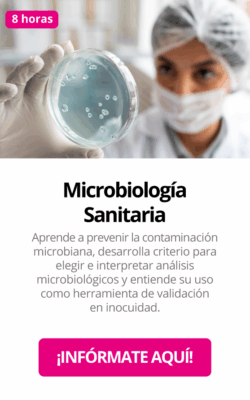

Meraki
Capacitación que transforma equipos en líderes de inocuidad
Diseñamos cursos prácticos y dinámicos para que tu equipo aprenda haciendo, mejore sus competencias y aplique lo aprendido en su día a día.
Beneficios de nuestra capacitación

Aprendizaje práctico
Tus colaboradores resuelven casos reales de la industria.
Motivación y compromiso
Se fomenta la participación activa, evitando cursos aburridos.

Curva de aprendizaje acelerada
Retroalimentación inmediata y aplicable

Conocimiento actualizado
Contenido alineado con normativas nacionales e internacionales.

Impacto directo en resultados
Mejora en auditorías, reducción de errores y cultura de inocuidad más fuerte.
Nuestra metodología de capacitación

CURSOS
Meraki
Modalidades de capacitación

ONLINE / PRESENCIALES

ONLINE
CERTIFICADOS Y RECONOCIMIENTOS
▪ Cursos avalados por la STPS para emitir la constancia DC-3 ▪ Curso HACCP aprobado por la International HACCP Alliance con certificación de sello dorado ▪ Cursos oficiales FSPCA



Más de 500 horas de capacitación para empresas de alimentos en sectores como cárnicos, lácteos, congelados, RTE, entre otros
CERTIFICADOS ADICIONALES (OPCIONAL)
Curso de Implementación de HACCP se les entregará un certificado con el sello de la HACCP Alliance. Con un costo adicional de (20 USD)
Curso del Programa de Verificación de Proveedores Extranjeros ( FSVP) se les entregará un certificado con un costo adicional de (60USD).
Curso de Ley de Inocuidad de Frutas y Vegetales PSA se les entregará un certificado con un costo adicional de (35USD).

Av. Villaplata #300 Plaza Mattia interior 11 y 12, Jesús María, Aguascalientes.